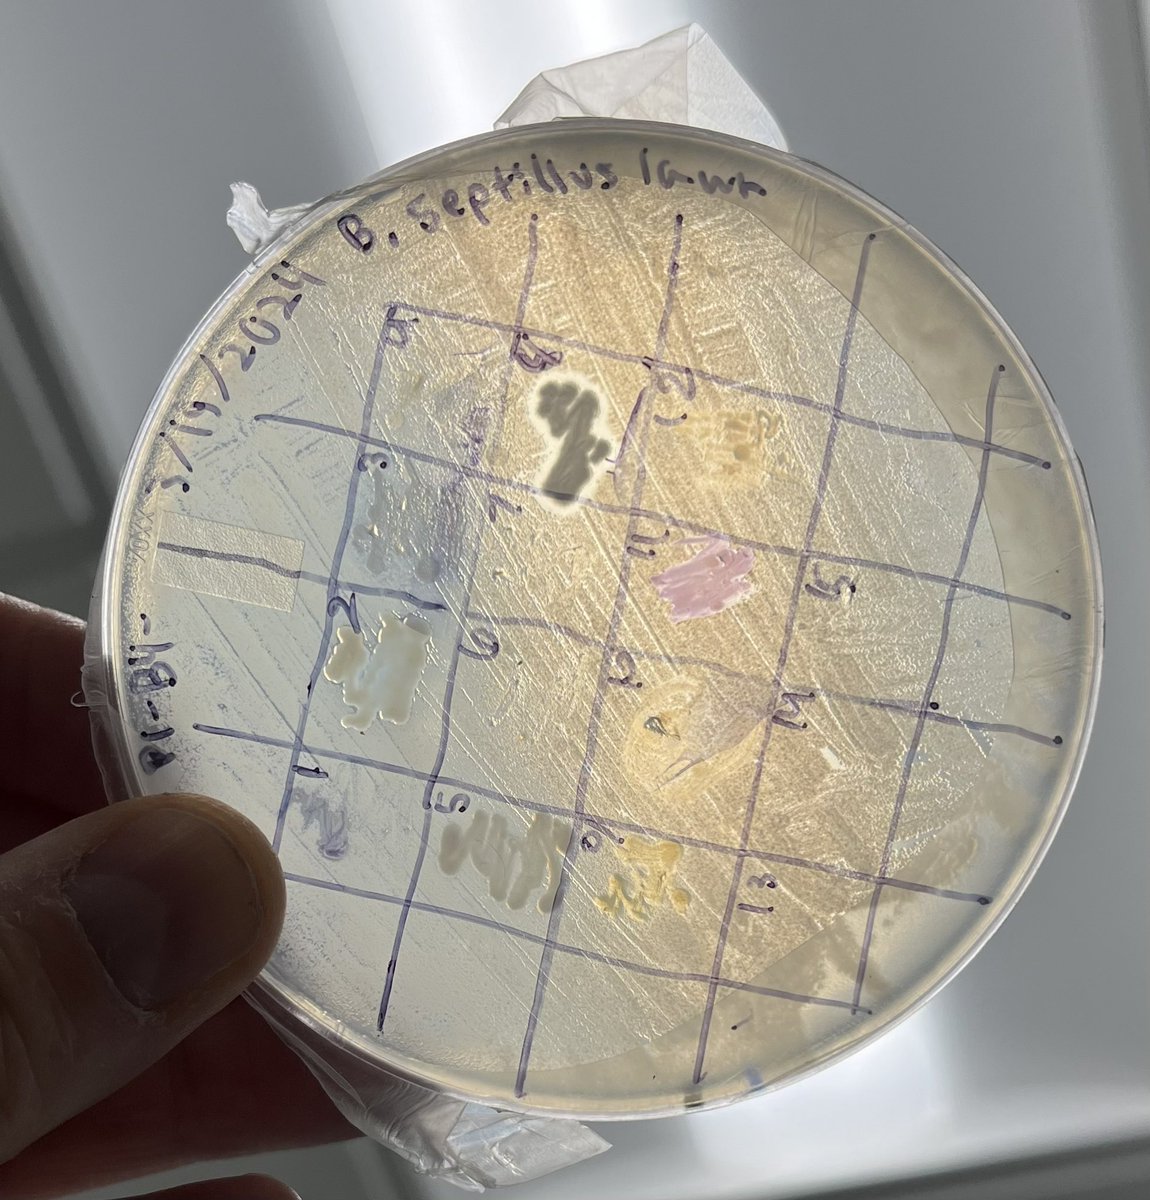
KuhnboBio's tweet image. Maybe some @TinyEarthNet antibacterial action?
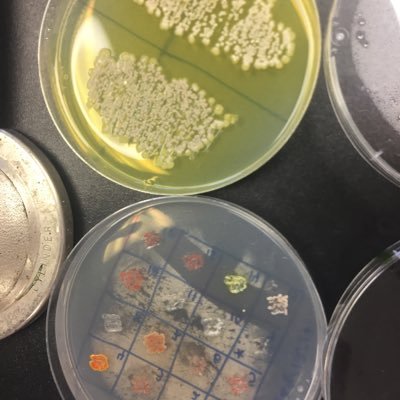
JHU_Tinyearth's profile picture. JHU CURE for antibiotic discovery. Johns Hopkins affiliated Tiny Earth (@TinyEarthNet) course. Soil microbes. Antibiotic Discovery. STEM Education.

Tiny Earth
@TinyEarthNet
Our network is studentsourcing antibiotic discovery through an inspiring and innovative science curriculum. HQ at @WIDiscovery @UWMadison.
You might like
Happy International Microorganisms Day! Tiny but mighty microbes play a huge role in the research Tiny Earth students and instructors conduct every day. We’re excited to see the discoveries they will make this fall!

The Tiny Earth community is thrilled to welcome a diverse group of 43 new TEPIs who trained this summer at UW-Madison. Each new TEPI brings expertise from a range of scientific fields to our network and represents institutions across 16 states and four countries.


Isolate 31104 from students in Dr. Loralyn Cozy’s classroom at Illinois Wesleyan University has entered the discovery pipeline at the Tiny Earth Chemistry Hub. TECH extracted high molecular weight genomic DNA from the strain and is preparing the gDNA for PacBio sequencing.

Last week, we hosted our annual Tiny Earth symposium where students and TEPIs from all across the country joined us in Madison, WI to celebrate antibiotic discovery. Thank you to our sponsors, Symposium Committee, and everyone who attended for making this event so great.
Featured TEPI: Dr. Jodi Enos-Berlage, a distinguished Biology Professor and researcher at Luther College, dedicates her career to investigating and addressing social and environmental issues in soil science and beyond. Read more about Dr. Enos-Berlage at tinyearth.wisc.edu/regenerating-s…

‼️REGISTRATION EXTENDED‼️ 📣 REGISTER by MAY 24! 📅 June 12-13, 2024 📍 Madison, WI | UW-Madison 🌐 tinyearth.wisc.edu/summer2024 Join us for the Tiny Earth Summer Symposium: a two-day event designed to showcase student research findings and antibiotic discovery!

Recently, TECH presented a poster at the Perlman Symposium on Antibiotic Discovery and Development. Martel DenHartog (TECH Lab Manager), Kristin Labby (TEPI in Residence), and Charlie Halaska (Undergraduate Researcher) shared exciting updates from TECH.

High school students from Green Bay, WI visited TE headquarters to learn more about antibiotic discovery Students participate in TE with the Serious About STEM program, a collaboration between UWGB and GB West HS that provides underrepresented girls in STEM with hands-on research



Happy Earth Day from Tiny Earth! We wish everyone a day full of appreciation for the Earth and its wonders.

Professor Betsy Martinez-Vaz’ #Microbiology class examines bacteria collected from soil from around campus in an effort to help create new antibiotics as part of @TinyEarthNet. Learn more about Hamline’s biology department: bit.ly/_Hamline_Biolo…
Tiny Earth had a blast at the Science Expeditions Campus Open House (@sciencewiscedu) this past weekend! Visitors got to identify soil by feel, view soil (including bacteria!) under a microscope, and take a look at antimicrobial resistance from plates with bacterial growth.



Searching for antibiotic producing microbes in the soil as part of intro biology at @univpugetsound! @TinyEarthNet @ASMicrobiology

☀️ 2024 Tiny Earth Summer Symposium 📣 REGISTER by May 10th! 📅 June 12-13, 2024 📍 Madison, WI | UW-Madison 🌐 tinyearth.wisc.edu/summer2024 Join us for the Tiny Earth Summer Symposium: a two-day event designed to showcase student research findings and antibiotic discovery!

Wow! Look at those zones! Check out these exciting results from Innovation Academy STEM High School led by TEPI Bob Kuhn who trained at UW-Madison last summer.
Teaching Biotech 1 about antibiotic discovery assays and bacterial evolution. We will allow the bacteria to generate mutations in liquid culture and re-plate Thursday. Good prep for noticing ZOI for @TinyEarthNet coming up next week.

This past January, Mariah A. Knowles joined the TE team as the new Curriculum Lead, transitioning from her former role as a Facilitator at the Wisconsin Institute for Discovery’s Data Science Hub. Welcome to the team, Mariah! Read more about Mariah at tinyearth.wisc.edu/knowles

Sending love from Tiny Earth! Happy Valentine’s Day to all our TEPIs & Tiny Earthlings ❤️🧫 ••• Made with bacteria isolates #21384 from Florida Atlantic University and #52798 from Warren Wilson College




Laura Pickell and Anil Gollapudi of Carleton University are 2 of 12 TEPIs in Canada. Through additional outreach and projects, they’ve increased students’ engagement with microbiology and Tiny Earth Read more about their experiences with TE and student engagement on our website

The Tiny Earth article about the incorporation of AJEDI (antiracist, just, diverse, equitable, diverse, inclusive) principles into the higher education system is one of the most cited in the Journal of Microbiology Education!

United States Trends
- 1. Araujo 176K posts
- 2. Chelsea 609K posts
- 3. Barca 245K posts
- 4. Estevao 243K posts
- 5. Barcelona 439K posts
- 6. Ferran 75.6K posts
- 7. Yamal 187K posts
- 8. Oklahoma State 4,419 posts
- 9. Eric Morris 2,923 posts
- 10. Cucurella 94.8K posts
- 11. Flick 46.2K posts
- 12. Godzilla 24.8K posts
- 13. Rashford 24K posts
- 14. Kounde 47.9K posts
- 15. Pedri 51.7K posts
- 16. Enzo 65.9K posts
- 17. Skippy 4,335 posts
- 18. #CHEBAR 16.5K posts
- 19. Raising Arizona 1,704 posts
- 20. Happy Thanksgiving 24.8K posts
Something went wrong.
Something went wrong.